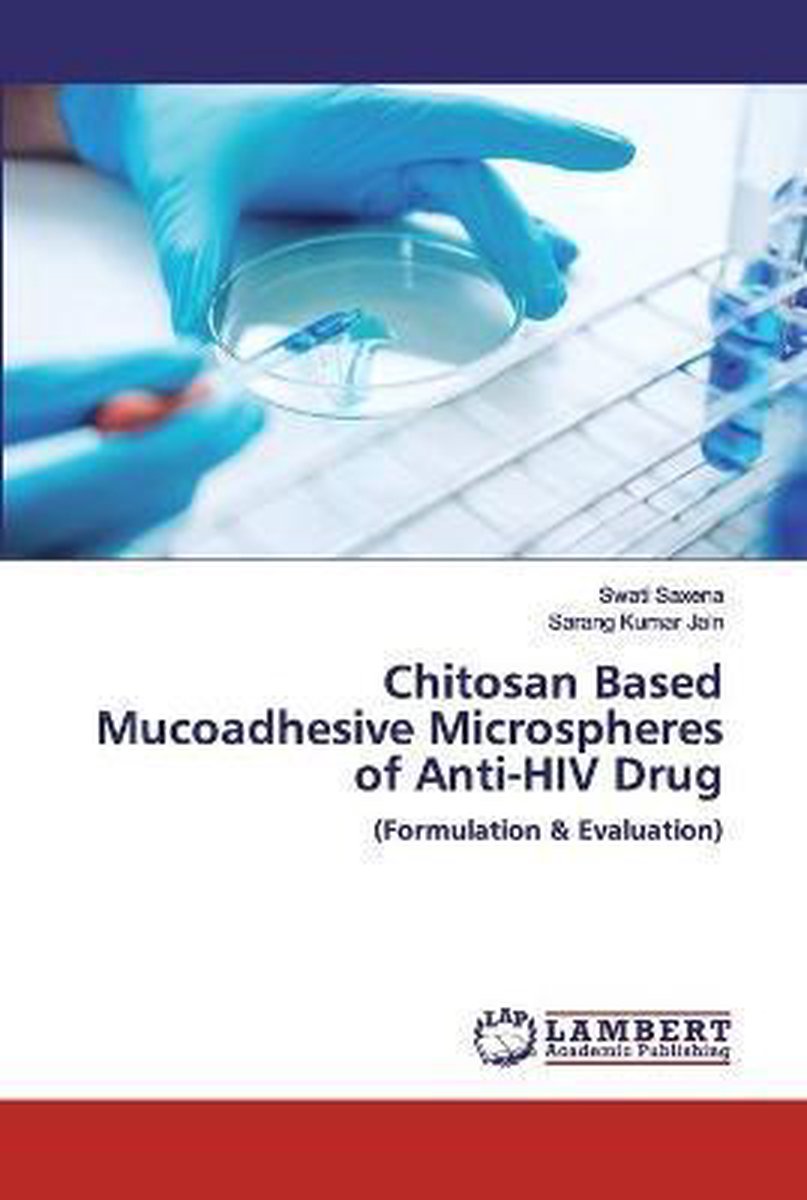

We hebben 6 boeken gevonden van de auteur Swati Saxena
Hieronder vindt u een lijst met alle gevonden boeken van de auteur Swati Saxena.
De meest gevonden boeken zijn C Programming And Coding:, C Programming And Coding Question Bank With Solution (2nd Edition), Kotlin At A Glance, Resilient & Sustainable Business Practices en Chitosan Based Mucoadhesive Microspheres Of Anti-hiv Drug.
De meest gevonden boeken zijn C Programming And Coding:, C Programming And Coding Question Bank With Solution (2nd Edition), Kotlin At A Glance, Resilient & Sustainable Business Practices en Chitosan Based Mucoadhesive Microspheres Of Anti-hiv Drug.
Sorteer op: